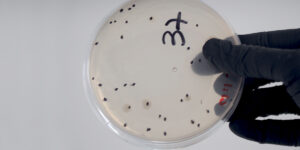

-
We have been awarded the EcoVadis Platinum Medal
2026/06/03 - cqmasso.com
In May 2026, we were awarded the EcoVadis Platinum Medal, placing us in the top 1% of companies assessed worldwide.
Read more -
Announcement of the Ordinary General Meeting of Shareholders 2026
2026/05/29 - cqmasso.com
The Ordinary General Shareholders' Meeting will be held in Barcelona, at the company's headquarters (c /. Viladomat, 321, 5º), next June 29 at 6:00 p.m. SEE MORE
Read more -
Massó Garden Collaborates with the “Darwin Botànic” Exhibition at the Hivernacle in Ciutadella, Barcelona
2026/03/12 - cqmasso.com
Massó Garden collaborates with the “Darwin Botànic” exhibition at the Hivernacle in Parc de la Ciutadella.
Read more -
Environmental Hygiene participates as an exhibitor and sponsor at Expocida 2026
2026/02/19 - cqmasso.com
The Environmental Hygiene Department will be at Expocida 2026 as an exhibitor and sponsor on February 26 and 27 in Madrid (IFEMA).
Read more -
2025 Christmas Postcards and Recipes Contest
2025/12/10 - cqmasso.com
We successfully held the 12th Edition of the Christmas Card Contest and the 4th Christmas Recipe Contest
Read more -
Probiotics for inflammation
2025/12/02 - greenplantsextracts.com
How gut health shapes your body’s defense system Inflammation is a natural part of the body’s defense system, but when it becomes chronic, it can lead to a host of health issues — from digestive disorders to mental health imbalances. Emerging research reveals that the gut microbiota plays a central role in modulating inflammation, and… Probiotics for inflammation The post Probiotics for inflammation appeared first on Green Plants Extracts...
Read more -
CQMassó Achieves EXCiPACT Certification
2025/11/12 - cqmasso.com
We are pleased to announce that we have been assessed and Certified by AENOR in accordance with the EXCiPACT Certification Standards for Pharmaceutical Excipient.
Read more -
Natural supplements for brain health
2025/10/23 - greenplantsextracts.com
In today’s world of constant cognitive demand and digital overload, maintaining optimal brain health is a rising concern for many. The global interest in nootropic supplements, compounds that may enhance mental performance, has led to the popularity of various natural extracts. Among these, saffron extract has emerged as a compelling option, backed by a growing… Natural supplements for brain health The post Natural supplements for brain health appeared first on Green Plants Extracts...
Read more -
Saffron as a natural supplement for brain health
2025/09/15 - greenplantsextracts.com
In recent years, there has been a growing interest in identifying natural and scientifically validated strategies to support brain health. Among the options studied, saffron (Crocus sativus L.) has emerged as a promising candidate. Traditionally valued for its culinary use and vibrant color, saffron is now recognized for its bioactive compounds that may positively influence… Saffron as a natural supplement for brain health The post Saffron as a natural supplement for brain health appeared first on Green Plants Extracts...
Read more -
Saffron as a natural ally for improving sleep quality
2025/08/11 - greenplantsextracts.com
Sleep disorders are increasingly common among the global population. The lack of restorative sleep exerts a detrimental effect on mental, cognitive, and physical health. Many patients opt for natural alternatives due to the limitations or side effects of traditional pharmaceutical treatments. In this context, saffron extract emerges as a promising option for improving sleep quality,… Saffron as a natural ally for improving sleep quality The post Saffron as a natural ally for improving sleep quality appeared first on Green Plants Extracts...
Read more -
A natural solution for women’s urinary health
2025/07/17 - greenplantsextracts.com
In today’s health landscape, urinary tract infections (UTIs) remain one of the most common bacterial infections among women. Affecting more than half of all women at least once in their lives, UTIs often become a recurring issue that significantly impacts daily comfort and well-being. While antibiotics have long been the go-to treatment, growing concerns about… A natural solution for women’s urinary health The post A natural solution for women’s urinary health appeared first on Green Plants Extracts...
Read more -
Saffron for fertility
2025/06/12 - greenplantsextracts.com
A natural boost for reproductive health Fertility is a topic of growing importance for many individuals and couples today. With increasing awareness around natural health and wellness, more people are turning to alternative remedies to support reproductive health. Among the most promising natural aids is saffron, a precious spice known not only for its culinary… Saffron for fertility The post Saffron for fertility appeared first on Green Plants Extracts...
Read more -
GPE at Vitafoods 2025 Barcelona
2025/05/14 - greenplantsextracts.com
Natural innovation and proven efficacy at stand 3K103 Green Plants Extracts (GPE) will be at Vitafoods 2025 in Barcelona, one of the most important events for the nutraceutical industry. It brings together key players from all over the world. You’ll find us at stand 3K103, where we’ll be sharing our latest innovations, designed for brands… GPE at Vitafoods 2025 Barcelona The post GPE at Vitafoods 2025 Barcelona appeared first on Green Plants Extracts...
Read more -
Sustainable Innovation: CQMassó and Oryzite
2025/05/08 - cqmasso.com
Sustainable Innovation: CQMassó and Oryzite — Bridging Chemistry and Nature to Transform the Industry.
Read more -
Probiotic supplements benefits
2025/04/11 - greenplantsextracts.com
The science behind wellness and ingredient innovation Interest in health has grown rapidly in recent years, and with it, the popularity of probiotic supplements. As research increasingly connects the gut microbiome to broader areas of physical and emotional well-being, more consumers are turning to probiotics to support everything from digestion and immunity to mental clarity… Probiotic supplements benefits The post Probiotic supplements benefits appeared first on Green Plants Extracts...
Read more -
Exploring Chemistry in the Business Environment!
2025/03/24 - cqmasso.com
Universitat of Barcelona Chemistry students had the incredible opportunity to visit the CHEMITAL facilities in Sant Pere Molanta (Barcelona).
Read more -
The effects of combined Scutellaria and Saffron supplementation on mood regulation
2025/03/17 - greenplantsextracts.com
Depressive symptoms affect millions of people worldwide, ranging from occasional sadness to persistent feelings of hopelessness that can interfere with daily life. While antidepressant medications and psychotherapy are the standard treatments for depression, concerns about side effects and a desire for more holistic options have led many individuals to explore natural alternatives...
Read more -
Plastics & Rubber 2025, March 12 & 13 in Barcelona
2025/03/13 - cqmasso.com
We will attend Plastics & Rubber 2025, the specialist forum of the plastic and rubber industry.
Read more -
Saffron extract as a natural treatment for ADHD
2025/02/17 - greenplantsextracts.com
Attention deficit / hyperactivity disorder (ADHD) is a common neurodevelopmental condition that affects both children and adults. Characterized by symptoms such as inattention, impulsivity, and hyperactivity, ADHD can significantly impact academic, professional, and personal life. While conventional treatments, including stimulant medications and behavioral therapy, are widely used, there is a growing interest in natural alternatives… Saffron extract as a natural treatment for ADHD The post Saffron extract as a natural treatment for ADHD appeared first on Green Plants Extracts...
Read more -
International Day for Biodiversity
2023/05/22 - fcr.cqmasso.com
Ingredients that protect & rebuild BIODIVERSITY by CQMASSO Care To know more, press the link below!. Open our e-NEWS We work for BIODIVERSITY protection & recovery
Read more -
A new era: Psychobiotics
2022/11/23 - fcr.cqmasso.com
The gut-brain axis solution. Psychobiotics provide benefits to the mental health. A new target for the cosmetic industry?. To know more, press the link below!. Open our e-NEWS of Spain, France, Romania, Hungary and Czech Republic
Read more -
C.Q.Massó sponsors the preservation of a centenarian Mediterranean forest
2022/02/22 - fcr.cqmasso.com
Comercial Química Massó S.A collaborates with SÈLVANS by sponsoring the preservation of a centenarian Mediterranean forest of at least 15 hectares. C.Q. Massó has just signed a 5-year collaboration agreement with SÈLVANS, thus becoming actively involved in the conservation and stewardship of the highest ecological value forest that exist in Catalonia...
Read more -
CARE BEYOND HYGIENE
2021/04/27 - fcr.cqmasso.com
During this time we see how household, industrial and institutional cleansing brands are innovating to fight Covid-19, that’s a good opportunity to aid consumer decision making with new tools that track the virus. We all know that they are essential products, that give us security and confidence in our day to day. So, why don’t…
Read more -
ISO 9001:2015 Certificate for our microbiology laboratory
2021/02/23 - fcr.cqmasso.com
We are delighted to announce that our microbiology laboratory has obtained the Quality Certification in accordance with the ISO 9001:2015 standard. At C.Q.Massó, we believe in quality. Our operations in the personal care industry are ISO 9001 certified since long ago; that concerns the manufacturing and commercialisation of ingredients, as well as the design and…
Read more -
E-NEWS | PANTONE COLOR OF THE YEAR 2021
2021/01/18 - saequim.com
Ultimate Gray 17-5104 & Illuminating 13-0647
Read more -
E-NEWS | We join the DONAMALES campaign
2020/12/22 - saequim.com
#donamales #sjdhospitalbarcelona #littlewarrior #chilhoodcancer
Read more -
REFORMULATING SUNSCREENS
2020/09/30 - fcr.cqmasso.com
It is time to reformulate sunscreens and our lab has already started to do so. We are designing formulations that meet the latest trends: high or very high SPF, new formats, elegant textures, naturality… Let’s share experiences and knowledge! Discover our eNews and call us right now. Reformulating Sunscreens Spain Reformulating Sunscreens France
Read more -
LET’S DEVELOP INNOVATIVE LAUNDRY PRODUCTS!
2020/09/03 - fcr.cqmasso.com
In the post-Covid-19 world, laundry products have become essential. In fact, this is a growing market, with expected volume and value increases in the coming years. What do consumers expect from laundry products? What drives their purchasing decisions? High efficacy for superior consumer safety Innovation: formats & ingredients. Ingredients and concepts from other markets, such…
Read more -
C. Q. MASSÓ Discover 2020 launches from our principals
2020/09/01 - fcr.cqmasso.com
Everything was ready for In-Cosmetics 2020, and now we make it available to you. Get to know the latest innovations in personal care ingredients. Don’t miss our 2020 launches newsletter! 2020 Launches – France 2020 Launches – Romania 2020 Launches – Poland
Read more -
eNews: Natural Deodorants
2020/09/01 - fcr.cqmasso.com
Ecology, Sustainable development and Naturalness: the secret of innovation, also for deodorants Organic and vegan are key growing trends, capturing a real consumer demand for natural and #cleanbeauty products, which exhibit at the same time a high efficacy linked to #biotech ingredients C.Q. Massó supports you getting there! Open our polish e-NEWS Open our hungarian…
Read more -
eNews: Deódorants au Naturel
2020/06/15 - fcr.cqmasso.com
Ecology, sustainability and naturality: the deodorants joint the key trends of the personal care industry offering new clean, vegan and highly efficient products. Get to know C. Q. Massó France’s solutions to innovate in the design and development of natural deodorants. Open our e-NEWS
Read more -
E-NEWS | Go #Upcycling
2020/03/10 - saequim.com
Join FULL CIRCLE and SAEQUIM in the commitment to Zero Waste Beauty!
Read more -
E-NEWS | PANTONE COLOUR OF THE YEAR 2020
2020/01/22 - saequim.com
Classic Blue 19-4052: color of the year 2020
Read more